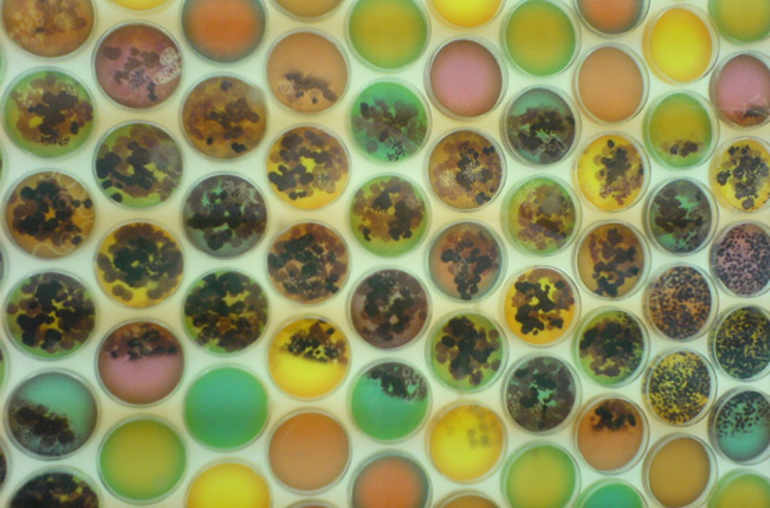

Comment le microbiote intestinal modifie notre personnalité
Une conception triomphante, simpliste et martiale de la médecine étendait son manteau rassurant sur l’humanité. Et qu’est-il arrivé? Le sida, d’abord, qui donna un terrible démenti à cette vision. Mais aussi l’émergence de quantité d’autres maladies, liées aux nouveaux modes de vie, à la mondialisation, à la déforestation ou encore à l’industrialisation de la filière alimentaire. Puis s’est imposé de manière croissante le problème des infections nosocomiales, causées par des bactéries s’adaptant aux conditions des hôpitaux modernes. En même temps que s’ouvrait un gigantesque champ d’inquiétude, dont on ignore encore jusqu’où il s’étendra: celui de la résistance aux antibiotiques.
Ce n’est pas tout. De plus en plus, on se rend compte que les bactéries et virus jouent un rôle dans des pathologies que nul ne pensait infectieuses, en une l’époque fascinée par la conception endogène des maladies. Il y eut la découverte du rôle d’Helicobacter pylori dans le cancer de l’estomac. En progressant, on s’est aperçu qu’au moins 20% des cancers ont une cause infectieuse. Peut-être plus, en un sens large, si l’on considère que près de la moitié de notre génome est composé de transposons (éléments génétiques mobiles, traces d’anciennes formes d’infections).
Mais le changement le plus troublant, probablement, pour notre vision anthropologique, vient de la colonisation de notre tube digestif, depuis le développement in utero, par des centaines d’espèces bactériennes spécifiques, parfaitement adaptées à notre organisme comme nous le sommes à leur présence. Explorée récemment grâce à la génétique, cette flore, que l’on appelle microbiote, ne cesse de prendre de l’importance en médecine. Chaque année apporte son lot de révélations sur son interaction avec notre organisme. Les bactéries qui la composent sont nécessaires à notre survie. Elles nous aident à digérer les glucides végétaux, à synthétiser des vitamines, à détoxifier de nombreuses substances. Par un effet «barrière», en occupant le terrain, elles protègent notre intestin des souches pathogènes.
Gérer les relations avec ces bactéries n’est pas chose simple. Dès les premiers stades de sa formation, le système immunitaire doit apprendre à les contrôler. Il lui faut entretenir avec elles un «dialogue symbiotique», surveiller leur diversité, éviter de les éradiquer tout en les empêchant de submerger leur hôte.
De cette complexité vitale, de ces mécanismes de contrôle découle une nouvelle approche des pathologies. On le comprend de mieux en mieux: la dysbiose, ou mauvaise gestion du microbiote, joue un rôle central dans des pathologies telles que l’obésité, la stéatose hépatique ou les maladies inflammatoires intestinales, ou encore, bien sûr, dans les infections (prise de pouvoir de quelques espèces au sein de la biodiversité intestinale).
Associé aux autres flores commensales – buccale, génitale et cutanée – le microbiote fait de nous ce qu’un de ses spécialistes, Philippe Sansonetti appelle un «superorganisme»:1 un complexe symbiotique issu d’une longue coévolution, cohérent, stable, capable de résilience, entre un corps – le nôtre – et une flore contenant 10 fois plus de cellules, et dont les gènes, mis ensemble, sont 100 fois plus nombreux que ceux de notre génome.
En résumé: nous sommes des vivants comme les autres, par notre biologie, par nos gènes, par nos pathologies mais aussi, au-delà, par notre manière de nous mélanger intimement et en temps réel aux vivants les plus «méprisables»: les bactéries.
Soyons francs: tout cela dérange. Comment en effet décrire au mieux l’anthropologie dominante, celle qui nous définit tout en nous faisant rêver? C’est une manière de se concevoir – y compris au plan biologique – comme un système informatique. La grande utopie du moment se réfère non à un corps biologique en équilibre avec son environnement, mais à son hybridation avec la technique. La technique a deux avantages: elle est notre production, nous pouvons grâce à elle devenir nous-mêmes notre propre produit. Et elle peut atteindre la perfection, là où la biologie doit se limiter à viser une imparfaite santé.
Voilà peut-être pourquoi, ces bactéries, nous nous sommes entêtés à les considérer de manière condescendante. Ou à les voir comme forcément hostiles. Car enfin, durant l’époque technologique, s’est imposée une vision hygiéniste, faisant de la stérilité de l’environnement un idéal. Dans cette ambiance, la conception qui, en nous décrivant comme des organismes symbiotiques, nous fait ressembler à du corail, constitue une véritable vexation narcissique.
La vexation ne s’arrête pas là. Comme le rapporte le New Scientist,2 les bactéries intestinales se montrent capables d’influencer la personnalité des animaux. En l’absence de microbiote, les souris développent un comportement anormal. Elles apparaissent désinhibées, manifestent des capacités d’apprentissage limitées. Mais il suffit de leur transmettre une flore intestinale pour qu’elles retrouvent un comportement normal. Plus intriguant encore: si l’on transfère le microbiote de souches de souris agressives à des souris sélectionnées pour leur pacifisme, le comportement agressif suit les bactéries. Par quel mystère? Eh bien, il semble que le microbiote change le niveau de protéines cérébrales impliquées dans l’humeur et l’anxiété. Conclusion de l’auteur de l’article, Stephen Collins: «les bactéries intestinales produisent des molécules qui agissent sur le cerveau». «Une personnalité est une chose vraiment compliquée», ajoute James Kinross, un chercheur spécialiste du microbiote. «Ce qui nous fait être nous-mêmes n’est pas simplement déterminé par des bactéries, mais elles peuvent jouer un rôle dans le développement de nos personnalités».
Il n’est donc pas impossible que l’on sache un jour prédire certains des troubles somatiques ou psychiques susceptible d’affecter un enfant en analysant son méconium. Voire que l’on parvienne à influencer sa santé en changeant le régime de sa mère, ou en modifiant sa flore intestinale…
Mais du monde microbien, rappelle Sansonetti, nous ne pouvons pas nous contenter d’une gentille et angélique approche coopératrice. Bien au contraire. Immensément diversifiés et capables d’évolutions rapides, les microbes s’adaptent à toutes les contraintes que nous cherchons à leur imposer. Du coup, «si nous n’avançons pas, le recul sera fatal». Justement, voilà le véritable problème: nos réussites temporaires, notre sentiment de supériorité, notre approche autocentrée nous empêchent d’admettre que nous perdons du terrain dans notre relation aux microbes.
Les bactéries et les virus trouvent des parades à nos molécules. En même temps, qu’il soit lié à la pauvreté, à la mondialisation ou à la dégradation de l’environnement, le risque de nouvelles émergences infectieuses s’accroît.
Nous avons cru, au 20e siècle, trouver la réponse aux infections. Quelle prétention! La vie n’est pas une affaire de réponses: c’est un jeu de questions, de surprises emboîtées. C’est un rapport ininterrompu entre organismes amis-ennemis qui, laissé à sa propre dynamique, ne fait de cas ni des individus ni des espèces.
Notes
1. Voir sa superbe leçon inaugurale au Collège de France: Des microbes et des hommes. Guerre et Paix aux surfaces muqueuses. http://lecons-cdf.revues.org/193.
2. Hamzelou J. Born dirty, with a gutful of bacteria. New Scientist, 14 avril 2012,6-7.
Source
RMS-339

Dans le secret de nos intestins

Les mystères (infinis) du microbiote




